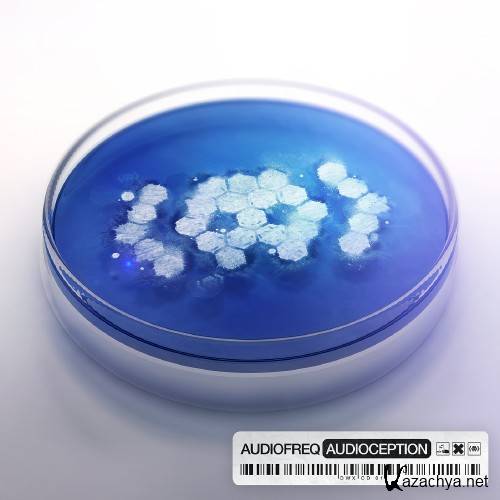
Audiofreq – Audioception (2013) FLAC Audiofreq – Audioception (2013) FLAC

Исполнитель: Audiofreq
Название: Audioception
Год выхода: 21-10-2013
Лейбл: Dirty Workz
Жанр: Hardstyle, Techno
Формат|Качество: FLAC
Количество треков: 21
Размер: 619.0 MB
Продолжительность: 01:17:33
МенюОпрос на сайтеАрхив новостей
Декабрь 2025 (290)
Ноябрь 2025 (448) Октябрь 2025 (455) Сентябрь 2025 (482) Август 2025 (500) Июль 2025 (35) РекламаВы вошли как Гость. Добро пожаловать к нам на сайт!
Метки и тегиКалендарь
|